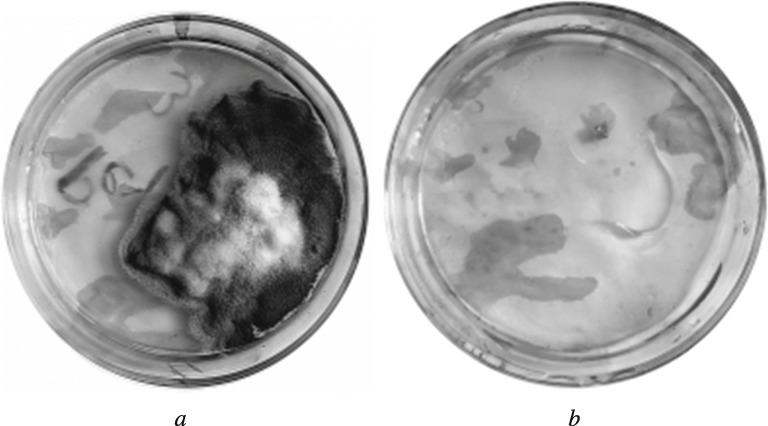
Fig. 7.

Abstract
Methods for preparing stable colloidal solutions containing bimetallic copper–silver nanoparticles via reduction due to the difference of oxidation potentials of the pairs Ag+/Ag0 and Cu2+/Cu0 and via synthesis in polymeric materials, namely polyamide and viscose fabrics and cellophane and polyamide films, are discussed.
Bimetallic nanoparticles (NPs) with a core–shell structure have huge potential for applications in various industrial sectors because of their strength as compared to monometallic NPs. Bicomponent NPs have attracted interest for basic research and practical applications in areas such as biosensors, catalysis, antitumor therapy, and targeted drug delivery. NPs are effective even with very low concentrations of them because of the large surface area.
NPs have dimensions small enough to enable penetration of bacterial membranes and interaction with bacterial DNA, thereby preventing them from multiplying, disrupting their metabolism, and destroying them from within.
Silver (Ag) NPs are used as a bactericidal agent in the textile industry and medicine [1, 2]. Ag NPs have been reported to possess antitumor activity and can inhibit the growth of cancer cells [3]. They also have antiviral activity, including against COVID-19 and SARS-CoV-2 [4]. Ag at low concentrations is nontoxic for humans and even increases immunity if taken daily.
Copper (Cu) also possesses bactericidal and antifungal activity [5]. In addition, Cu is an important trace element necessary for humans as an enzyme cofactor of the respiratory chain and plays an important role in hemoglobin synthesis.
Bacterial strains, i.e., mycobacteria, that are resistant to Ag NPs have been observed in the last decade [6, 7]. They have emerged because of the use of antibacterial agents containing colloidal Ag. Such mutated strains are not susceptible to the action of Ag NPs but are easily affected by bimetallic NPs that contain another metal besides Ag to which the bacteria have not shown resistance [8]. Thus, the use of bicomponent metal NPs as antimicrobial agents is promising.
The synthesis of bimetallic NPs is currently insufficiently explored. Scientific and technical information about ways for producing such NPs is scarce.
Mainly two approaches are used to produce Ag and Cu NPs, i.e., physical and chemical. Chemical methods for reducing Ag salts in H2O or organic solvents are used most often for Ag NPs [9, 10]. Mainly microemulsion methods are used to synthesize Cu NPs. However, they require the use of large quantities of environmentally hazardous surfactants and organic solvents [11, 12]. Cu NPs are extremely reactive, readily oxidized by oxygen in air and water, and prone to aggregation. Therefore, stable solutions of Cu NPs are difficult to prepare and require carefully selected stabilizers and the addition of antioxidants.
Physical methods such as laser ablation, radiolysis, and aerosol methods are also effective for producing metallic NPs with well controlled dimensions although they are energy-intensive and require expensive equipment [13].
An advantage of chemical synthesis is the low cost of the starting material and low energy losses as compared to physical methods. Recently, research in this area has focused on replacing toxic chemical reductants by ecologically friendly ones such as ascorbic acid, glucose, lactose, etc. [14–17].
Preparation of stable colloidal solutions containing bicomponent Cu–Ag NPs
Production of bimetallic Cu–Ag NPs in solution without using specific reductants and taking advantage of the difference in the oxidation potentials (E0) of the pairs Ag+/Ag0 (+0.7994 V) and Cu2+/Cu0 (+0.3450 V) was studied experimentally by us [16, 17]. A solution (0.1%) of poly(vinyl alcohol) (PVA) was used as the most effective stabilizer [17].
An analytical balance was used for weighing to an accuracy of 10–4 g. Optical densities (A) of colloidal solutions were measured using a KFK-3 ZOMZ photometer designed to analyze liquid solutions.
The crystal lattice of metals, including Ag and Cu, is constructed so that valence electrons can migrate throughout the whole substance, which is responsible for their high electrical conductivity. The variable electric field of a light beam dislodges conductivity electrons so that dipoles vibrating at the frequency of the incident light field form on the NP surface. These dipoles are called surface plasmons. A similar effect arises if the size of the NP is much less than the wavelength of the incident light. Resonance absorption and light scattering occur if the vibrational frequency of surface plasmons and the frequency of the incident light coincide. This is called surface plasmon resonance (SPR) [19]. Ag NPs have the strongest SPR at 390-420 nm.
Bimetallic NPs were prepared by preparing a solution of CuSO4·5H2O in aqueous PVA (0.1%), heating it to boiling on a water bath, adding AgNO3 solution, boiling the mixture again, and making it basic to pH 11. It was found that basic solution was the most effective for forming the bimetallic NPs [16, 17].
The color of the solutions changed during the reaction from colorless to golden yellow and then to brown with a metallic sheen and an absorption maximum in the range 400-420 nm. This could indicate that the surface of the synthesized bicomponent NPs consisted of zero-valent Ag. It could be assumed that Cu was reduced faster in the solution and formed nuclei because of its higher reactivity and the smaller difference of the oxidation potentials (E0) of the pair Cu2+/Cu0 (+0.3450 V) vs. E0 Ag+/Ag0 (+0.7994 V) [18]. Then, Ag0 coated the surface of the Cu NPs, thereby growing the bicomponent NPs.
The kinetics of formation of the Cu–Ag NPs in a colloidal solution with initial concentrations of 0.0003 M (CuSO4·5H2O) and 0.0002 M (AgNO3) were studied (Fig. 1, Table 1). A solution of AgNO3 was added to a previously heated solution of CuSO4·5H2O made basic to pH 11. The mixture was boiled. An aliquot was taken after various time intervals (1 min). The optical density was measured. The content of Ag+ was determined by titration using the Volhard method; of Cu2+, using iodometry [20].
Fig. 1.

Dependence of optical density at λmax = 420 nm on reaction time.
Table 1.
Determination of Amount of Reduced Copper and Silver Cations in Colloidal Solutions
| Reaction time, min | Amount of Ag+ | Amount of Cu2+ | ||
|---|---|---|---|---|
| initial , mg/mL | reduced cations, % | initial, mg /mL | reduced cat ions, % | |
| 0 | 0.03907 | 0 | 0.0112 | 0 |
| 1 | 0.00594 | 85 | 0.0006 | 95 |
| 2 | 0.00425 | 89 | 0.0006 | 95 |
| 3 | 0.00425 | 89 | 0.0004 | 96 |
| 4 | 0.00340 | 91 | 0 | 100 |
| 5 | 0.00340 | 91 | 0 | 100 |
| 6 | 0.00255 | 93 | 0 | 100 |
The results for the dependence of the optical density shown in Fig. 1 and the titration of the aliquots (Table 1) led to the conclusion that Cu2+ was fully reduced already four minutes after the start of the reaction. The optical density at λmax = 420 nm increased sharply. Ag+ cations continued to react to form the bimetallic NPs, coating the Cu NPs as a thin layer so that they were practically fully reduced by the sixth minute. The optical density measured 24 h after the reaction confirmed that the reaction was complete in six minutes, after which detectable changes in the colloidal solution were not observed.
The colloidal solutions prepared in this manner were checked for stability. The optical density showed a maximum at λ = 400-420 nm upon storage for more than a year at room temperature.
Modification of polymeric materials by bicomponent Cu–Ag NPs
The syntheses of bimetallic Cu–Ag NPs in the structure of polyamide fiber fabric, viscose staple fabric, and cellophane and polyamide films were studied. Reduction of Cu2+ and Ag+ from solutions of their salts (CuSO4·5H2O and AgNO3) with concentrations in the range 0.0001-0.0006 M was used to impart antibacterial and antifungal properties to the polymeric materials.
Let us assume that the synthesis involved diffusion of the ions into the porous polymer structure, reaction with substrate functional groups acting as reductants for the metallic NPs, and binding by physical and strong chemical bonds because of this. The size of the bicomponent Cu–Ag NPs in the fibrous volume was limited by the pore size. However, larger agglomerates could form on the surface.
Viscose fiber is an artificial fiber with numerous alcohols. The hydroxyls contained in it act as reductants of metal cations.
Polyamide fiber (Capron) belongs to a large group of fibers with many repeating amides –CO–NH– in the main chains and terminal amines –NH2, which can reduce metal cations to NPs. The fibers have low hygroscopicity. Their small pore size allows the sizes of the formed NPs to be regulated over a very narrow range.
Cellophane film, like viscose fiber, contains OH groups. In addition, it includes sulfur as highly reducing sulfides that produce metallic NPs. Cellophane films are produced using regenerated (recovered) cellulose, a 100% natural material and product of primary processing of wood or cotton. Cotton cellulose contains 2-3% impurities while wood cellulose has 15-20% impurities.
Polyamide film also contains terminal amines –NH2 that can reduce metal cations to NPs.
It was proposed that Cu–Ag NPs were strongly bound in the structure of polymeric materials because of the reaction of metal cations with functional groups of the substrate itself and the reduction to the zero-valent form because of the difference in the oxidation potentials (E0) of the pairs Ag+/Ag0 (+0.7994 V) and Cu2+/Cu0 (+0.3450 V) [18]. According to the literature, the considerable difference between the E0 values of the pairs Ag+/Ag0 and Cu2+/Cu0 indicates that Cu2+ is less reactive in reactions with reductants and that metallic Cu and Cu+ can reduce Ag+.
The obtained bimetallic NPs did not contain hazardous impurities on their surface because extraneous chemicals were removed during preparation of the working solutions.
Like in the colloidal solutions, a color change was observed during synthesis of the NPs in the structure of the polymeric materials. The color varied from golden yellow to dark brown. The shade of color was controlled by changing the reaction conditions and precursor concentrations. The final color was characterized by reflectance spectra recorded using a UV-2401PC spectrophotometer (Shimadzu) (Fig. 2). Band maxima in reflectance spectra of all studied samples fell in the range 400-430 nm. This could indicate that the surface of the synthesized bicomponent NPs consisted of Ag0, like for the colloidal solutions.
Fig. 2.

Dependence of reflectance coefficient R on wavelength λ for cellophane film: starting sample (1), sample modified at pH 7 (2), sample modified at pH 9 (3).
The influence of adding NH3·H2O to the reaction vessel to pH 8-9 to enhance the formation of bimetallic NPs was studied. Figure 2 shows reflectance spectra of cellophane film samples with concentrations of 0.0003 M (Cu) and 0.0006 M (Ag).
The plots in Fig. 2 show that the color was more intense at pH 9, arguing in favor of larger amounts of NPs as compared to the neutral solution.
Also, NH3·H2O had a stabilizing effect and prevented aggregate formation. The Ag+ was presumably complexed by NH3 after adding NH3·H2O to the AgNO3 solution:
AgNO3 + 2(NH3 ⋅ H2O) = [Ag(NH3)2]NO3 + 2H2O.
Then, [Ag(NH3)2]+ reacted with Cu2+ that were uniformly distributed in the porous structure of the polymeric material and were reduced to bimetallic NPs because of the difference between the oxidation potentials. The obtained polymeric materials acquired a deeper and uniform color.
The best results were obtained for the following salt concentrations: CuSO4·5H2O, 0.0003-0.0006 M; AgNO3, 0.0001-0.0006 M. The optimal basic pH was 10-11 for the polyamide film. These conditions produced a uniform distribution of Cu–Ag NPs in the porous structure and on the substrate surface. Aggregates of bimetallic particles formed at higher concentrations according to the nonuniform color of the modified samples.
Microscope studies using a JSM-639 OLA scanning electron microscope (JEOL) revealed the formation of bicomponent Cu–Ag NPs of sizes from 30 to 100 nm. Figure 3 shows photomicrographs of modified polymeric materials.
Fig. 3.
Photomicrographs of films modified by bimetallic nanoparticles at concentrations of 0.0002 M (CuSO4·5H2O) and 0.0003 M (AgNO3): cellophane film at pH 7 (a) and polyamide film at pH 10-11 (b).
Energy-dispersive x-ray spectroscopy and x-ray mapping of the composition of the modified polymeric materials used an S-4700 field-emission scanning electron microscope (Hitachi) based on the use of the field-emission effect of electrons in a strong electric field. Figures 4 and 5 show the x-ray emission spectrum and x-ray mapping of the elemental composition of modified bimetallic NPs of polyamide fiber fabric. The concentrations of starting Ag and Cu salts were 0.0005 M in basic solution during treatment of the fabric.
Fig. 4.

X-ray emission spectrum of polyamide fiber fabric modified by Cu–Ag bimetallic nanoparticles.
Fig. 5.
X-ray mapping of elemental composition of modified polyamide fiber fabric: C (a), O (b), and Ag (c).
Data obtained using a field-emission scanning electron microscopy confirmed that bimetallic NPs with Ag as the shell formed on the surface of polyamide fiber fabric (Fig. 4) and also showed a rather uniform distribution of the NPs on the surface and in the structure of the substrate (Fig. 5).
Samples of modified viscose staple fabric and polyamide fiber fabric were studied according to GOST R ISO 105-C06-2011 for resistance to laundering. High resistance parameters (5/5/5 for most polymeric materials) were obtained even for laundering under the most severe conditions (240 min, 95°C). This confirmed the fastness of the bimetallic NPs in the porous structure and on the substrate surface. Figure 6 shows reflectance spectra of polyamide fiber fabric samples for salt concentrations 0.0003 M (Cu) and 0.0006 M (Ag).
Fig. 6.
Dependence of reflectance coefficient R on wavelength λ for samples of modified polyamide fiber fabric: before laundering (1), after laundering (2); modification using NH3·H2O (a) and NaOH (b).
The functions shown in Fig. 6 show that the changes in the reflectance coefficient minima after laundering were ≤ 2%. This was indicative of strong binding of the bicomponent NPs in the material structure. Slightly deeper colored samples were obtained if NaOH was used.
Viscose fibers are very easily affected by the action of various microorganisms. Samples of viscose staple fabric were tested for resistance to microbiological destruction according to GOST 9.060–75 Unified system of corrosion and ageing protection (USCAP). Fabrics. Method of laboratory tests for microbiological destruction stability. The method consists essentially of fabrics under defined conditions being subjected to the action of a natural complex of soil microflora by depositing a special mixture on the fabric surface and then determining the resistance to microbiological destruction from the change of tensile strength. The tests lasted 10 d. The tensile strength was determined on a PT-250M tester. Tests were conducted for samples of viscose staple fabric modified by bicomponent Cu–Ag NPs and monometallic Ag and Cu NPs.
Samples modified by monometallic Cu and Ag NPs had resistance coefficients to microbiological destruction (henceforth P) of 12.65 and 8.37%, respectively. A synergistic effect was observed for the bimetallic Cu–Ag NPs. The obtained antimicrobial properties strengthened to P = 94.04%.
The bactericidal activity of the modified samples of viscose staple fabric was studied according to GOST ISO 20645-2004 Textile fabrics. Determination of antibacterial activity. Agar diffusion plate test. This involved immersion of test samples into broth with test cultures.
Test samples of surface area 2 cm2 were placed into broth culture containing Gram-positive S. aureus and Gram-negative E. coli bacteria in the amount of 1·108 CFU/mL (CFU = colony-forming unit). The controls were tubes with bacteria and without test samples. A rack with tubes was placed on a shaker (250 rpm) for 24 h. An aliquot (1 mL) of the suspension was taken from each tube and inoculated on the surface of a Petri dish with meat-peptone agar. The inoculations were incubated in a thermostat at 37°C for 24 h. Grown colonies of microorganisms multiplied by the dilution factor were counted on the following day. The data were reported as CFU/mL.
The amounts of Gram-positive and Gram-negative bacteria were reduced by several orders of magnitude as compared to the control after 24 h. A bactericidal effect could be observed during the testing. The number of grown Gram-negative E. coli microorganisms (CFU/mL) on modified viscose staple fabric (6·107) was noticeably less than in the control (2·109). The number of Gram-positive S. aureus microorganisms (7·107) was also less than in the control (4·108).
Laboratory tests of the polymeric materials for resistance to the action of mold fungi were conducted according to GOST 9.048–89. Unified system of corrosion and ageing protection. Technical items. Methods of laboratory tests for mold resistance. A sample of the tested fibrous material of area 1 cm2 was placed in the center of a Petri dish onto previously prepared growth medium. A suspension of Penicillium chrysogenum spores was sprayed onto the sample. Then, the Petri dish was placed into a desiccator onto the bottom of which water was poured. The tests were conducted at 29 ± 2°C and relative humidity >90% for 28 d.
Figure 7 shows photographs of the starting and modified cellophane fabrics subjected to the action of mold fungi. The photographs show that the sample of modified cellophane film was resistant to the action of mold fungi.
Fig. 7.
Photographs of cellophane films affected by mold fungi for 28 d: starting sample (a) and sample modified by bimetallic nanoparticles (b).
The observed antifungal effect of the bicomponent NPs was significantly greater than that obtained previously by us using monometallic Ag and Cu NPs for polymeric materials.
The work was performed in the framework of the Priority 2030 Program.
Footnotes
Translated from Khimicheskie Volokna, No. 3, pp. 17-23, May—June, 2022.
References
- 1.Silvestry-Rodriguez N, Bright KR, et al. J. Environ. Sci. Health, Part A: Toxic/Hazard. Subst. Environ. Eng. 2007;42(11):1579–1584. doi: 10.1080/10934520701517689. [DOI] [PubMed] [Google Scholar]
- 2.O. V. Mosin, NanoWeek, No. 3, 34-37 (2008).
- 3.Khan MS, Alomari A, et al. Pharmaceutics. 2021;13(5):707. doi: 10.3390/pharmaceutics13050707. [DOI] [PMC free article] [PubMed] [Google Scholar]
- 4.O. Zachar, ScienceOpen Preprints, No. 1, 1-17 (2020).
- 5.Mahmoodi S, Elmi A, Hallaj-Nezhadi S. J. Mol. Pharm. Org. Process Res. 2018;6(1):140. doi: 10.4172/2329-9053.1000140. [DOI] [Google Scholar]
- 6.Larimer C, Islam MS, et al. Biometals. 2014;27(4):695–702. doi: 10.1007/s10534-014-9761-4. [DOI] [PubMed] [Google Scholar]
- 7.Silver LL. Clin. Microbiol. Rev. 2011;24(1):71–109. doi: 10.1128/CMR.00030-10. [DOI] [PMC free article] [PubMed] [Google Scholar]
- 8.Z. Xiong, “Ag-Cu bimetallic nanoparticle synthesis and properties,” Doc. Dis., Univ. Pittsburgh, 2017, 177 pp.
- 9.Krutyakov YA, Kudrinskii AA, et al. Usp. Khim. 2008;77(3):242–269. doi: 10.1070/RC2008v077n03ABEH003751. [DOI] [Google Scholar]
- 10.S. D. Utochkin, T. A. Sherstneva, and M. Yu. Koroleva, Usp. Khim. Khim. Tekhnol., 24, No. 7 (112), 122-126 (2010).
- 11.Jignasa NS, Sengupta R, Murthy Z. Solid State Sci. 2010;12(9):1560–1566. doi: 10.1016/j.solidstatesciences.2010.06.021. [DOI] [Google Scholar]
- 12.Song XY, Sun SX, Zhang WM, et al. J. Colloid Interface Sci. 2004;273(2):463–469. doi: 10.1016/j.jcis.2004.01.019. [DOI] [PubMed] [Google Scholar]
- 13.Rafique M, Rafique MS, et al. Opt. Quantum Electron. 2019;51(179):1–12. [Google Scholar]
- 14.Zain NM, Stapley AGF, Shama G. Carbohydr. Polym. 2014;112:195–202. doi: 10.1016/j.carbpol.2014.05.081. [DOI] [PubMed] [Google Scholar]
- 15.E. V. Erokhina, V. N. Galashina, et al., Ross. Khim. Zh., LX, No. 5-6, 9-16 (2016).
- 16.Kudriavtseva EV, Burinskaya AA. Sci. Heritage. 2021;1(58):39–45. [Google Scholar]
- 17.E. V. Kudryavtseva and A. A. Burinskaya, Vestn. S.-Peterb. Gos. Univ. Tekhnol. Dizain., No. 2, 101-106 (2021).
- 18.Yu. Yu. Lur’e, Handbook of Analytical Chemistry [in Russian], Khimiya, Moscow, 1989, pp. 277-283.
- 19.Technology of Nanostructures: Methodical Recommendations [in Russian], Stavropol’` , 2017, pp. 14-16.
- 20.V. F. Yustratova, G. N. Mikileva, and I. A. Mochalova, Analytical Chemistry. Quantitative Chemical Analysis: Study Aide [in Russian], KemGU TIPP, Kemerovo, 2005, 161 pp.